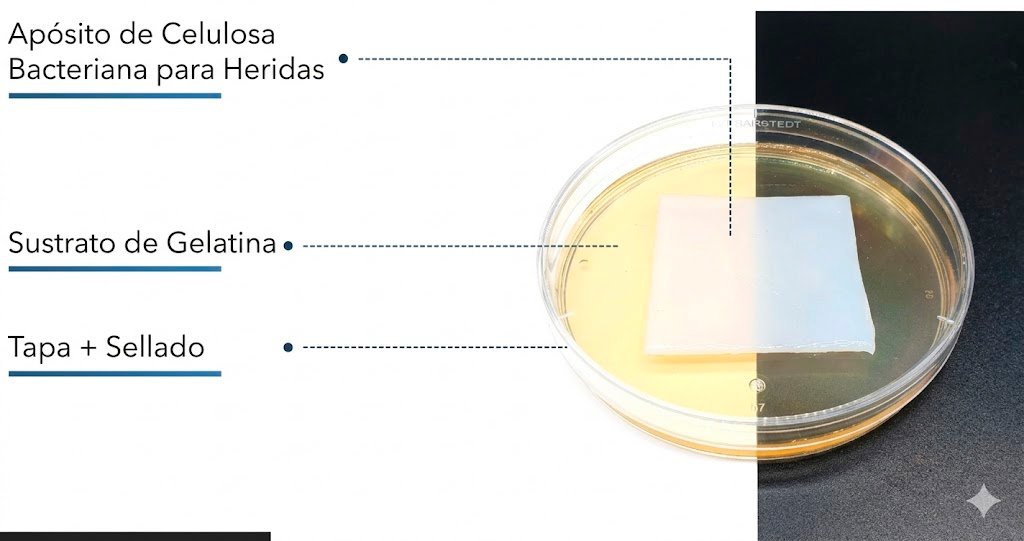
21. Celulosa bacteriana: Adaptación de un material idéntico al natural a las necesidades del cuidado avanzado de heridas crónicas

1. Aplicación de apósitos a base de nanocelulosa bacteriana en el tratamiento de lesiones térmicas: Experiencia en 92 niños
Revista: BURNS 2022 | Alemania
La nanocelulosa bacteriana actúa como un sustituto temporal de la epidermis, permitiendo que la piel cicatrice sin necesidad de cambios frecuentes de apósito, no requiere el uso adicional de antimicrobianos tópicos en niños con adecuada evolución

2. Un nuevo modelo de quemadura humana ex vivo y el efecto de enfriamiento local de un apósito para heridas basado en nanocelulosa bacteriana
Revista: BURNS 2020 | Austria
La nanocelulosa bacteriana enfría eficazmente la quemadura sin necesidad de pre-enfriamiento, reduce el daño térmico y ayuda a prevenir la progresión de la quemadura.

3. Evaluación de la cicatrización en áreas de quemaduras de segundo grado con el uso de xenoinjerto en comparación con sustituto de piel de celulosa sintética
Revista: German Medical Science 2020 | Perú
El sustituto cutáneo sintético es una alternativa superior para mejorar la calidad de cicatrización y favorecer una recuperación más rápida en pacientes con quemaduras de segundo grado.

4. Usabilidad y eficacia de Epicite Hydro en lesiones térmicas en niños en un importante centro de quemados alemán
Revista: German Medical Science Joiurnal 2020 | Alemania
La nanocelulosa (Epicite hydro®) es segura, fácil de usar, reduce hospitalización y necesidad de anestesia, tiene baja tasa de infección y favorece buena cicatrización con menor costo global de tratamiento.

5. Nanocelulosa para quemaduras: Epicite hydro
Revista: German Medical Science Joiurnal 2020 | Mexico
El artículo trata sobre la evaluación clínica de Epicite-hydro, un apósito de nanocelulosa bacteriana, utilizado como sustituto cutáneo en pacientes con quemaduras. el artículo demuestra que la nanocelulosa (Epicite-hydro) es una alternativa moderna y efectiva como sustituto cutáneo en el tratamiento de quemaduras.

6. Tratamiento de quemaduras con BNC (bacterias nanocelulosas) Epicite: Experiencia clínica inicial con un nuevo producto
Revista: German Medical Science Joiurnal 2020 | Alemania
El artículo presenta una serie de casos clínicos sobre el uso de BNC (nanocelulosa bacteriana, Epicite) en el tratamiento agudo de quemaduras. El artículo presenta una serie de casos clínicos sobre el uso de BNC (nanocelulosa bacteriana, Epicite) en el tratamiento agudo de quemaduras.

7. Epicite Hydro en el tratamiento de lesiones térmicas en niños: ¿Un nuevo estándar de atención?
Revista: German Medical Science Joiurnal 2020 | Alemania
El estudio describe la experiencia en un centro especializado en quemaduras pediátricas utilizando Epicite Hydro® (nanocelulosa) en comparación con apósitos de espuma de poliuretano (Biatain®) en quemaduras de segundo grado (2a–2b) en tronco y extremidades. Epicite Hydro® es una alternativa eficaz y más amigable para niños con quemaduras, ya que reduce procedimientos dolorosos, anestesias y tiempo de hospitalización, consolidándose como nuevo estándar de tratamiento en el centro evaluado.

8. Epicite-hydro, primer apósito para la preparación del lecho de la herida en quemaduras de espesor total
Revista: German Medical Science Joiurnal 2020 | Mexico
En hospitales con escasa disponibilidad de piel cadavérica o regeneradores dérmicos, Epicitehydro es una opción efectiva y segura para preparar el lecho de la herida en quemaduras de espesor total, facilitando la posterior colocación de injertos.

9. Experiencias con Epicite en la aplicación cotidiana en un centro de grandes quemados
Revista: BURNS 2019 | Alemania
Epicite Hydro® es un apósito seguro, cómodo y eficaz, que mantiene la humedad, reduce el dolor y favorece resultados estéticos positivos, siendo útil tanto en quemaduras de segundo grado como en enfermedades exfoliativas graves.

10. Monitorización continua del pH en heridas mediante un apósito indicador compuesto: Estudio de viabilidad
Revista: BURNS 2019 | Austria
El estudio explora una nueva aplicación de Epicitehydro, un apósito de nanocelulosa bacteriana, funcionalizado con un indicador de pH (GJM-534) para monitorear el pH de la herida sin retirar el apósito. Es posible integrar monitoreo de pH en un apósito avanzado de nanocelulosa, lo que podría mejorar el seguimiento de la cicatrización de quemaduras.

11. Influencia de los apósitos secundarios en el efecto de un apósito de celulosa derivado de bacterias: Resultados de un estudio en animales
Revista: BURN- CARE & RESEARCH 2019 | EE. UU.
El tipo de apósito secundario junto con la nanocelulosa bacteriana modula la humedad y la evaporación, lo que puede acelerar o retrasar la cicatrización. Seleccionar la combinación correcta es clave para optimizar la curación de quemaduras y heridas crónicas.

12. Epicitehydro© para el tratamiento conservador de heridas en niños con quemaduras de segundo grado
Revista: BURNS 2021 | Alemania
El material probado no solo promete un entorno óptimo para una cicatrización de heridas sin interrupciones. Debido a la posibilidad de dejar el vendaje en las heridas durante hasta 7 días, la piel subyacente puede regenerarse sin poner en peligro la nueva capa formada mediante la manipulación frecuente durante los cambios de vendaje.

13. Celulosa (Epicite) para el tratamiento de zonas donantes y quemaduras: Nuestras experiencias iniciales
Revista: German Medical Science Joiurnal 2018 | Alemania
La nanocelulosa debido a su alto contenido de agua, el material posee excelentes propiedades como apósito, representando una alternativa prometedora para el tratamiento de quemaduras, además de su potencial uso como vehículo para fármacos o antisépticos.

14. Un nuevo modelo de quemadura humana ex vivo y el efecto de enfriamiento local de un apósito para heridas basado en nanocelulosa bacteriana
Revista: BURNS 2020 | Austria
Los apósitos de BNC enfrían eficazmente las quemaduras mediante efecto evaporativo, sin necesidad de preenfriamiento, reduciendo tanto la temperatura intradérmica como el daño térmico y la progresión de la quemadura. Representan una alternativa segura y prometedora en el manejo inicial de quemaduras.

15. Administración de soluciones antisépticas mediante un apósito de celulosa bacteriana para la herida: captación, liberación y eficacia antibacteriana de octenidina y povidona-yodo
Revista: BURNS 2019 | Alemania
Debido al alto contenido de agua, el material tiene excelentes propiedades como apósito y es una alternativa prometedora para futuros usos en quemaduras.

16. El impacto de un apósito para heridas a base de nanocelulosa en el manejo de lesiones térmicas en niños: resultados de una evaluación retrospectiva
Revista: LIFE 2020 | Alemania
El uso de apósitos a base de nanocelulosa para el tratamiento de quemaduras tanto superficiales y de espesor parcial como profundas y de espesor total presenta varias ventajas, tiene una baja tasa de infección asociada y favorece la cicatrización de las heridas.

17. Apósito biosintético de celulosa en una sola etapa como primera capa versus manejo con gasa no adherente en quemaduras pediátricas
Revista: BURN 2021 | Dubai
La aplicación de un apósito biosintético de celulosa como primera capa se asocia con una reducción del dolor, menor ansiedad parental y mejor calidad de cicatrización. El apósito es seguro y puede aplicarse en pacientes con quemaduras superficiales y de espesor mixto.

18. Modificaciones superficiales de la nanocelulosa para aplicaciones en liberación de fármacos: Una revisión crítica
Revista: SIENCE DIRECT 2023 | Filandia
La nanocelulosa tiene un gran potencial para convertirse en un nuevo vehículo de administración de fármacos gracias a su biocompatibilidad, baja toxicidad, estructura química ajustable y sostenibilidad.

19. Uso de xenoinjerto comparado con sustituto dérmico sintético de nanocelulosa en pacientes con quemaduras térmicas de segundo grado profundo, enero 2022-julio 2023
Revista: REVISTA HORIZONTE 2025 | Perú
Se evidenció que el sustituto sintético dérmico de nanocelulosa es una alternativa importante que favorece la calidad de cicatrización en las zonas afectadas por quemaduras. Resultó ser más eficiente que el xenoinjerto al ser evaluado y comparado en sus cuatro parámetros con la escala internacional de evaluación de cicatrización de Vancouver.

20. Uso de un nuevo apósito para quemaduras elaborado a partir de nanocelulosa bacteriana en comparación con el estándar francés de cuidado en quemaduras pediátricas de segundo grado: Un análisis retrospectivo
Revista: BURN 2022 | Francia
Los apósitos de nanocelulosa bacteriana representan una herramienta valiosa en el tratamiento de quemaduras pediátricas, logrando resultados satisfactorios, menor dolor y menor tiempo de hospitalización. Sus beneficios y evaluar su impacto económico.

21. Celulosa bacteriana: Adaptación de un material idéntico al natural a las necesidades del cuidado avanzado de heridas crónicas
Revista: MDPI 2022 | Alemania
Este artículo se centra en datos experimentales y clínicos sobre la aplicación del anticonceptivo en los síntomas de heridas crónicas que no cicatrizan, especialmente úlceras venosas y diabéticas.
22. Eficacia de la membrana de celulosa bacteriana para el tratamiento de úlceras varicosas crónicas de miembros inferiores: Un ensayo aleatorizado y controlado
Revista: PUBMEND 2017 | Brasil
Este estudio prospectivo, aleatorizado y controlado evaluó la eficacia de la membrana de celulosa bacteriana (BC) en el tratamiento de úlceras venosas crónicas de miembros inferiores en 25 pacientes, comparándola con apósitos convencionales con aceite de triglicéridos durante 120 días. La membrana de celulosa bacteriana es una alternativa segura y eficaz como apósito en úlceras venosas de miembros inferiores, con el beneficio adicional de mejorar el confort del paciente al reducir el dolor.

23. Administración de soluciones antisépticas mediante un apósito de celulosa bacteriana: Absorción, liberación y eficacia antibacteriana de la octenidina y la povidona yodada
Revista: BURN 2020 | Alemania
Los resultados obtenidos de la movilidad de las moléculas de FITC-dextrano en la matriz de BNC podrían abrir la puerta a posibles aplicaciones para la combinación de BNC con otras moléculas en aplicaciones médicas. La combinación de ambos antisépticos probados con BNC demostró ser un método eficaz para controlar las infecciones bacterianas.

24. Apósito de celulosa biosintética de una sola etapa y primera capa versus gasa no adherente para el tratamiento de quemaduras pediátricas
Revista: BURN 2021 | Dubai
La aplicación de una sola capa de apósito de celulosa biosintética se asocia con reducción del dolor, mejor cicatrización. El apósito es seguro y puede aplicarse a pacientes con quemaduras superficiales y de profundidad mixta.

25. Comparación de la calidad de cicatrización de quemaduras de segundo grado profundo con nanocelulosa EPICITE vs. Curación convencional en la ciudad de Puno 2022
Revista: REVISTA VIVE 2025 | Perú
El sustituto dérmico de nanocelulosa EPICITE es una alternativa eficaz para el tratamiento de quemaduras de segundo grado profundo, mejorando significativamente la calidad de la cicatrización frente a la terapia convencional.

26. El impacto de un apósito a base de nanocelulosa en el tratamiento de lesiones térmicas en niños: resultados de una evaluación retrospectiva
Revista: PMC 2020 | Alemania
Los resultados de este estudio sugieren un excelente impacto de Epicite hydro® en el tratamiento de lesiones térmicas en niños. Según nuestra experiencia, fue muy fácil de manejar; mostró una excelente hidratación y adherencia a la superficie de la herida, sin necesidad de un desbridamiento extenso; y requirió pocos cambios de apósito.

26. Eficacia de la nanocelulosa bacteriana (BNC) como agente terapéutico eficaz para la cicatrización de heridas: Una revisión sistemática
Revista: REVISTA VIVE 2025 | Perú
La nanocelulosa bacteriana (NBC) es un biomaterial prometedor como sustituto de piel artificial debido a su alta capacidad de retención de agua, resistencia mecánica, biodegradabilidad e histocompatibilidad.
Esta revisión bibliográfica integrativa, basada en estudios publicados en los últimos cinco años (PubMed, ProQuest y SciELO), evaluó los resultados clínicos de la NBC en el tratamiento de heridas, especialmente quemaduras.

27. Comparación del dolor con epicite hydro y cura convencional en quemaduras de segundo grado profundo
Revista: REVISTA VIVE 2025 | Perú
Se evidenció la mejoría del dolor con la escala de (EVA), con el uso del sustituto de nanocelulosa. Se destaca la existencia del dolor leve para el grupo que usó la nanocelulosa en contraste con el dolor moderado que fue característico en los casos con tratamiento de cura convencional.



